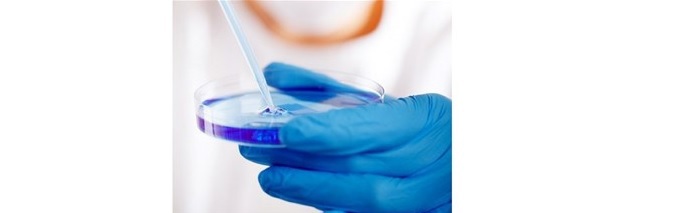
Bilde av forsøk i naturfagtimen.

Stipendet ble etablert i 2007 og har som hensikt å stimulere, hjelpe og rekruttere PSL'ere til forskning. Det er vanlig å gi stipendmidler for 1-5 mnd. pr. søker. Forskningsstipendene er innrettet slik at det gis støtte med kr 50.000,- pr. mnd. I tillegg gis det støtte til adm.kostnader og reise pr. stipend-mnd. med kr 2.500,-. Midlene utbetales direkte fra fond II. Det er PSLs forskningsutvalg som innstiller søker(e) og PSL-styret som fatter vedtak om tildeling.
PSL mener det er viktig at våre medlemmer, som ønsker å forske i en periode, gis mulighet til dette. Det kan gi nye utfordringer og variasjon i praksisen, kan åpne for samarbeid mellom sykehusmiljø og spesialistpraksis, og kan være både positivt og rekrutterende.
Dersom du har spørsmål om stipendet kan PSLs sekretariat kontaktes. Søknad bes sendt elektronisk til sekretariatet v/PSLs forskningsutvalg på epost: psl@legeforeningen.no.
Det gjøres oppmerksom på at man må selv søke RHF'et om permisjon og godkjenning av vikarbruk.